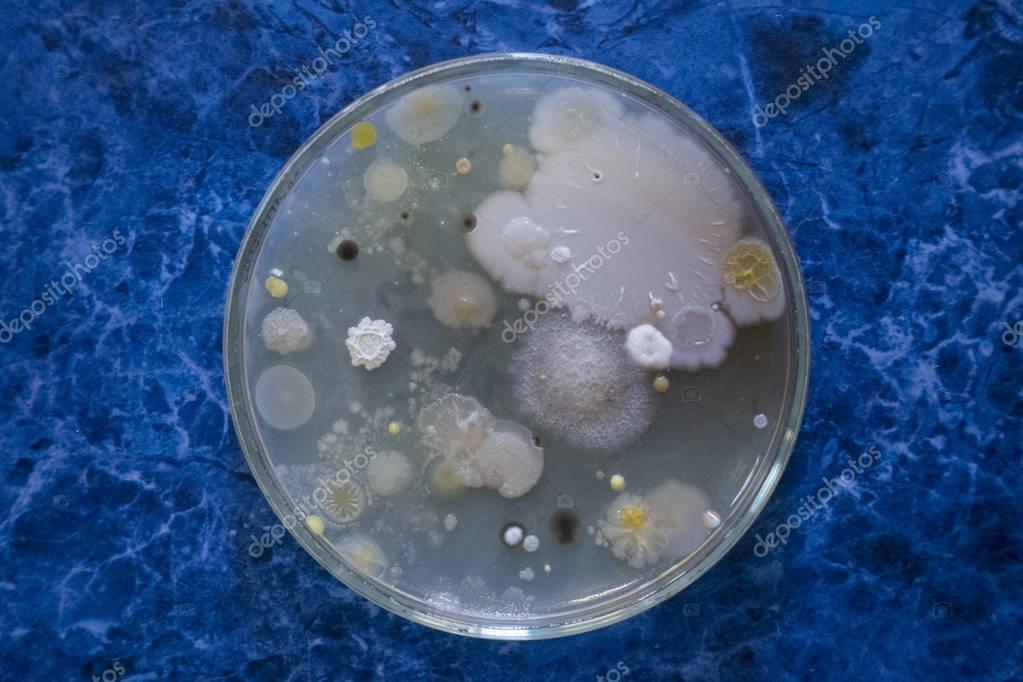
Colonies Bacteria Petri Dish Mold Bacilli — Stock Photo © NikolayAsasis

If you are looking for corynebacteria - meddic you've came to the right page. We have 9 Images about corynebacteria - meddic like Microscopic view of Bacilli bacteria. - Stock Photo - Dissolve, Rod shaped bacteria - Stock Image - F001/3692 - Science Photo Library and also Rod shaped bacteria - Stock Image - F001/3692 - Science Photo Library. Here you go:
Corynebacteria - Meddic
microbiology corynebacteria corynebacterium competency pseudo
Microscopic View Of Bacilli Bacteria. - Stock Photo - Dissolve
microscopic bacilli stocktrek dissolve d1243
Comparing The Genomes Of The Leprosy Bacteria
mycobacterium leprae leprosy bacteria cdc genomes comparing epfl subscription actu ch
Take The Ultimate Microbiology Quiz Questions! - ProProfs Quiz
 www.proprofs.com
www.proprofs.com stain proprofs microbiology ultimate
Rod Shaped Bacteria - Stock Image - F001/3692 - Science Photo Library
 www.sciencephoto.com
www.sciencephoto.com Salmonella - Bacteria : What Is Salmonellosis? | Salmonella Symptoms
 www.youtube.com
www.youtube.com salmonella bacteria salmonellosis symptoms
Print Prokaryote Lab - Representative Slides Flashcards | Easy Notecards
 www.easynotecards.com
www.easynotecards.com gram positive shaped diptheria representative
Colonies Bacteria Petri Dish Mold Bacilli — Stock Photo © NikolayAsasis
depositphotos.com
depositphotos.com petri colonies
Fusobacterium Nucleatum - Microbewiki
anaerobic gram fusobacterium negative nucleatum bacilli rods infections culture staining bacteria microbewiki bacteroides prevotella spp microbiology species bacterial clostridium non
Comparing the genomes of the leprosy bacteria. Petri colonies. Gram positive shaped diptheria representative